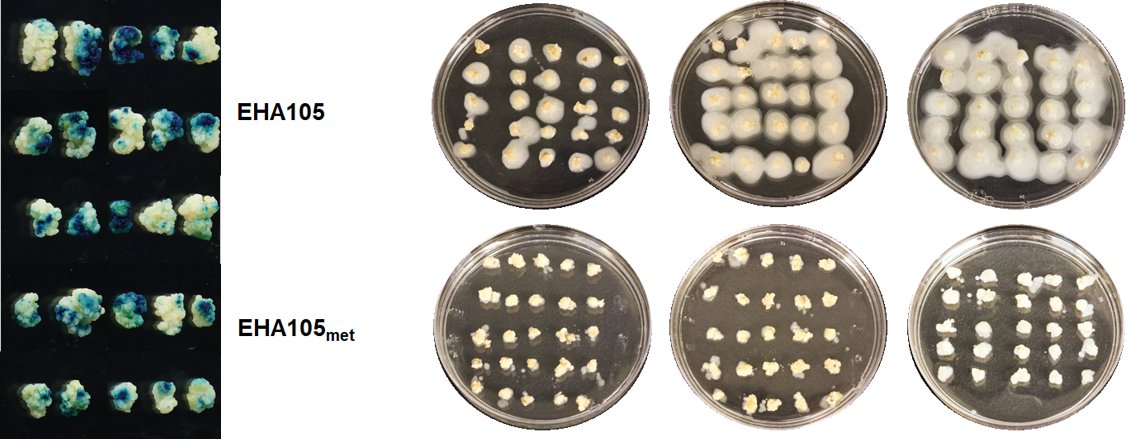
tim 🐈 tweet media

Gary Orr
26 posts

Gary Orr
@TallfescWho
genetics | plant biotech | synthetic biology UGA alum- Go dawgs!
Charleston, SC Katılım Ekim 2019
90 Takip Edilen45 Takipçiler
Gary Orr retweetledi

Learn more about our latest research grant from @stripe & Frontier.
Hint: it involves the toughest biopolymers in the world 🧪🧬💎 livingcarbon.com/post/the-diamo…
English
Gary Orr retweetledi
Gary Orr retweetledi
Gary Orr retweetledi

Happy to see our paper out😀Beautiful work by Monica in our lab!!! #agrobacterium biorxiv.org/content/10.110…
English
Gary Orr retweetledi

Global warming is the biggest threat of our time & trees are one of our natural weapons to capture carbon. What if they could help faster? We @living_carbon are excited to unveil that photosynthesis-enhanced trees can grow faster and capture more carbon. Here's how we did it 🧵
English
Gary Orr retweetledi

Today’s research is just the first step in demonstrating how empowering ecology, through the responsible use of biotechnology in trees, can be a scalable and viable solution to the climate crisis. #ClimateAction #ClimateTech

English

Seeing if a strain, Ach5, that has been in the freezer longer than I have been alive will wake up....
#agrobacterium

English

@TimFutureLeaf @espn I was saying the same damn thing!!! Luckily it didn't matter but refs were god awful.
English


@CharlestonPD Heard the shots, multiple guns followed by a pause and then 5-6 shots from a handgun. Terrifying.
English

CPD is currently in the area of Rice Drive and Ashley River Rd in reference to a shooting involving multiple victims. We will provide information as available. #chsnews
English
Gary Orr retweetledi
Gary Orr retweetledi

XPrize team will manage the $100M carbon capture prize
XPRIZE@xprize
The $100M XPRIZE Carbon Removal is now LIVE. Funded by @elonmusk, it’s the largest in history. Fight climate change. Let’s exit the fossil fuel era. 🌎 ♻️ Sign up now: bit.ly/3rvd3KO @PeterDiamandis @AnoushehAnsari #environment
English

@EvanMcSoy Nice! You working on those photoshop skills for the background?
English
Gary Orr retweetledi

#AcademicTwitter: I used to be a horrible scientific writer. I was paralyzed by writing anxiety & it took me FOREVER to write papers. Last year I published 14 scientific articles (8 first, 2 second, 2 senior-author) & 2 book chapters.
A thread⬇️on how I became more productive:
English

Don't need dicamba if you just roll some coal on those weeds
Calvin Horst@calhorst5
First day running the #weedzapper in #organic soybeans. It has potential I think.
English

@TallfescWho You're just mad you had to settle for tallfescWho because someone already took y'allfescue
English

Assuming I complete my PhD I think it's only fair that you should all call me Plague Doctor "Bones" McCoy #plaguedoctor
English






